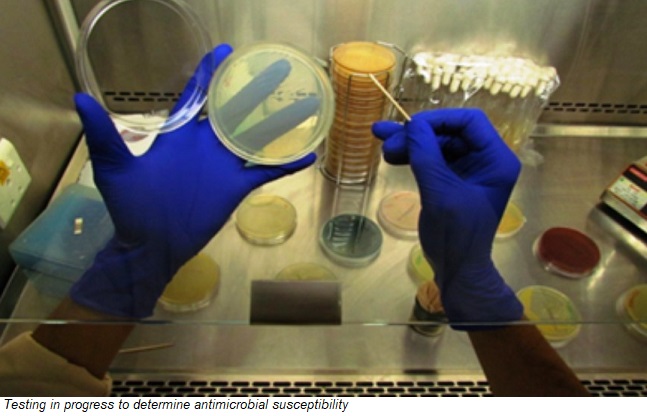

The Indian Pathogen Priority List (IPPL) released by Union Minister for Health and Family Welfare Dr Harsh Vardhan will guide the research, discovery and development of new effective and affordable antibiotics that support the country’s “Make in India” priorities.

The global impact of COVID-19 has brought greater recognition of the biotech sector’s direct influence on innovation- and technology-adoption for pharmaceuticals as well as other sectors, said Dr Harsh Vardhan. The IPPL will help align research and development on AMR with national and global public health needs and incentivise funding support to help contain the spread of antibiotic-resistant pathogens.

The IPPL report was launched in the presence of WHO Representative to India Dr Roderico H. Ofrin, and Secretary of the Department of Biotechnology, Dr Renu Swarup at the valedictory session of Global Bio-India 2021.
IPPL was developed by the WHO Country Office for India in collaboration with the Department of Biotechnology to boost research and and development of new antibiotics in and for India.
The report is aligned with WHO’s Global Priority Pathogen List of antibiotic-resistant bacteria and was developed with inputs from AMR experts across different domains from across India to guide policy initiatives that incentivise basic science and advanced research and development through public funding agencies and private-sector investment in new antibiotics pipelines.
India is one of the world’s largest consumers of antimicrobials, with easy over-the-counter availability of cheap antibiotics leading to indiscriminate use and misuse. India was the fifth largest consumer of antimicrobials in food animals (poultry, pigs, and cattle) in 2010, and with rising incomes and changing dietary patterns feeding an increase in the demand for animal protein, especially for poultry, antimicrobial use is projected to grow by 312% by 2030.
India has some of the highest antimicrobial resistance rates among bacteria that commonly cause infections in the community and healthcare facilities. Resistance to the broad-spectrum antimicrobials – fluoroquinolones and third generation cephalosporins – is reported to be more than 70% in Acinetobacter baumannii, Escherichia coli and Klebsiella pneumoniae, and more than 50% in Pseudomonas aeruginosa. Resistance to colistin – a last resort antimicrobial – has also emerged in India. High levels of antimicrobial resistance have also been reported in animals – especially poultry, livestock and aquaculture – and in the environment, which gets contaminated from wastewater and effluents from pharmaceutical companies making antimicrobials.
The containment of AMR needs a One Health approach across sectors – including human health, animal health, food and environment – at national, states and community levels. If we fail to address this rising threat of drug-resistant disease, we risk losing the gains made towards meeting the Sustainable Development Goals.